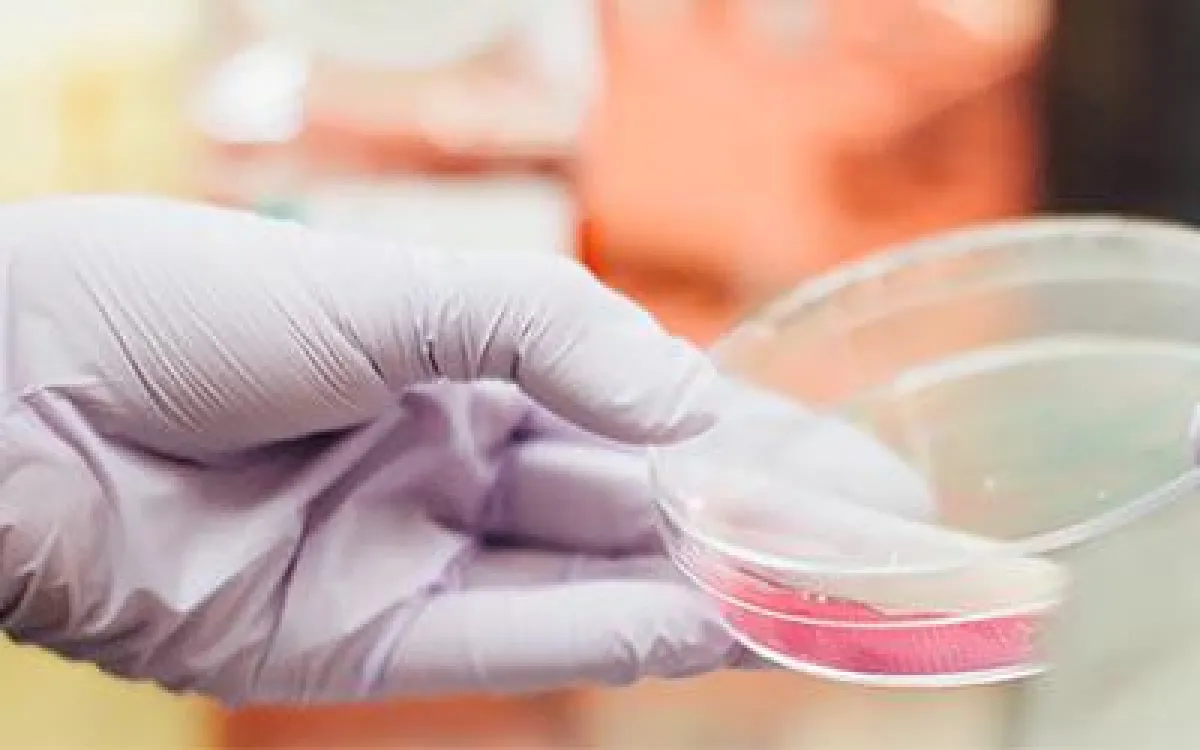

(openPR) Der Begasungsbrutschrank von BINDER, sprich der CO2-Inkubator, ist bei den Anwendern sehr beliebt. Damit der Nutzer dazu alle Informationen auf einen Blick bekommt, hat BINDER diese auf einer Pillar Page zusammengefasst. Sie ist eine Erweiterung der schon sehr ausführlichen Webseite von BINDER und bietet den Lesern viele neue Möglichkeiten. Begonnen wird mit einer Erklärung, was ein Brutschrank tatsächlich ist. Dabei klingt es durchaus einfach, denn in einem CO2-Inkubator wird eine möglichst naturgetreue Atmosphäre geschaffen, um die Entwicklung von Zell- und Gewebekulturen sicherzustellen. Allerdings müssen die Rahmenbedingungen wie Feuchte, Temperatur und CO2-Gehalt stimmen. Doch wer könnte dies besser als ein BINDER-Schrank!
Wer es noch genauer wissen will, kann sich unter dem Bereich Aufbau und Funktion eines CO2-Inkubators darüber informieren, ein Video zeigt unter anderem welche Besonderheiten der BINDER-Brutschrank aufweist. Hier wird einmal mehr deutlich, dass BINDER auf beste Materialien und eine hochmoderne Technik setzt. Besonders spannend wird es bei dem Thema, wie ein CO2-Schrank eingesetzt wird. Diese Sparte gibt dem Leser Einblicke in die Anwendungsbereiche der Inkubatoren und berichtet über zufriedene Kunden die auf jahrelange Erfahrung mit BINDER CO2 Schränken zurückgreifen. So werden die BINDER-Schränke z.B. im Bereich der künstlichen Befruchtung verwendet. Dass BINDER auch in der Krebsforschung ein deutliches Wort mitredet, wird ebenso deutlich.
Und welcher CO2-Inkubator ist jetzt der richtige? Auch auf diese Frage bekommen die Nutzer auf der neuen Seite Antworten. Klicken Sie hier und werfen Sie einen Blick darauf – es lohnt sich allemal.
Presseinformation
Alle Informationen zu Inkubatoren

Diese Pressemeldung wurde auf openPR veröffentlicht.
Verantwortlich für diese Pressemeldung:Anne Lenze
PR und Event Specialist
BINDER Central Services GmbH & Co. KG
Im Mittleren Ösch 5
D-78532 Tuttlingen
Phone: +49 7462 / 2005 - 632
Fax: +49 7462 / 2005 - 93 632
E-Mail:
www.binder-world.com
PR und Event Specialist
BINDER Central Services GmbH & Co. KG
Im Mittleren Ösch 5
D-78532 Tuttlingen
Phone: +49 7462 / 2005 - 632
Fax: +49 7462 / 2005 - 93 632
E-Mail:
www.binder-world.com
Über das Unternehmen
BINDER ist weltweit der größte Spezialist für Simulationsschränke für das wissenschaftliche und industrielle Labor. Mit den technischen Lösungen trägt das Unternehmen wesentlich dazu bei, die Gesundheit und Sicherheit der Menschheit nachhaltig zu verbessern. Das Produktprogramm eignet sich sowohl für Routineanwendungen als auch für hochspezifische Arbeiten in Forschung und Entwicklung, Produktion und Qualitätssicherung.
Pressebericht „Alle Informationen zu Inkubatoren“ bearbeiten oder mit dem "Super-PR-Sparpaket" stark hervorheben, zielgerichtet an Journalisten & Top50 Online-Portale verbreiten:
Disclaimer: Für den obigen Pressetext inkl. etwaiger Bilder/ Videos ist ausschließlich der im Text angegebene Kontakt verantwortlich. Der Webseitenanbieter distanziert sich ausdrücklich von den Inhalten Dritter und macht sich diese nicht zu eigen. Wenn Sie die obigen Informationen redaktionell nutzen möchten, so wenden Sie sich bitte an den obigen Pressekontakt. Bei einer Veröffentlichung bitten wir um ein Belegexemplar oder Quellenennung der URL.
Weitere Mitteilungen von BINDER GmbH

BINDER-Freezer tragen Energy-Star-Siegel
Die Ultratiefkühlschränke von BINDER sind besonders sparsam beim Stromverbrauch. Das bestätigt auch das Energy-Star-Siegel, ein US-amerikanisches Umweltzeichen für energiesparende Geräte. Unter den geprüften ULT-Freezern liegt der BINDER-Freezer mit 0,36 Kilowattstunden pro Tag und Kubikfuß auf einem der vorderen Plätze.
Die Konkurrenz, und das wird in diesem Vergleich schnell deutlich, benötigt zum Teil doppelt so viel Energie wie BINDER. Von allen deutschen Unternehmen, die sich mit dem Energy-Star-Siegel schmücken dürfen, liegt BINDER mit…

Einer für alle: der neue Vakuumtrockenschrank von BINDER
Die Nachfrage nach den BINDER-Vakuumtrockenschränken ist groß. Das liegt vor allem auch daran, dass BINDER der einzige Hersteller auf diesem Gebiet ist, der nachweislich ein explosionssicheres Gerät anbieten kann. Daher wird der VDL, wie er in Kurzform genannt wird, auch gerne zur Gewinnung von Cannabis-Extrakt in Teilen der USA sowie in Kanada genutzt.
Aufgrund der Nachfrage und des eigenen hohen Anspruchs, den BINDER an seine Produkte hat, wurde entschieden, die Produktgruppe der Vakuumtrockenschränke noch innovativer und moderner zu gestal…
Das könnte Sie auch interessieren:


Rotationsschüttler für Suspensions-Zellkulturen im CO2-Inkubator
Seit dem 1. April sind für CO2-Inkubatoren von BINDER maßgeschneiderte Schüttler als Zubehör erhältlich. Diese sind für die optimale Bebrütung von nicht-adhärenten Zellen notwendig.
Für CO2-Inkubatoren ab 150 L bietet BINDER seit dem 1. April optional CO2-Schüttler als Zubehör an. Diese Schüttler werden zur Inkubation nicht-adhärenter Zellen, sogenannter …


acatech Studie zur Unterstützung von akademischen Ausgründungen: Innovation braucht Mentoren
… eine Projektgruppe von acatech – Deutsche Akademie der Technikwissenschaften in ihrem heute veröffentlichten Positionspapier zur Förderung von akademischen Ausgründungen durch Inkubatoren. Erfahrene Unternehmer sollten als Mentoren die Spin-offs juristisch und betriebswirtschaftlich beraten und den Kontakt zu Experten wie Patentanwälten vermitteln.
Die …


Reinalgen aus Deutschland
… geschaffen. Im Besonderen ist es möglich das Risiko hinsichtlich eventueller Störungen und Kontamination der Algenzucht gänzlich einzugrenzen, da die Algenzucht in geschlossenen Schlauch-Inkubatoren Systemen erfolgt, die modulweise aufgebaut sind. Auf einem Modul sind vier Reihen Folienreaktoren angebracht. Diese werden von oben über eine Ringleitung mit …


Auf den Spuren der Mikroorganismen
Mikrobiologische Inkubatoren von BINDER
Die Mikrobiologie ist ein Teilgebiet der Biologie. Der sehr komplexe wissenschaftliche Bereich befasst sich mit der Erforschung von Bakterien, Pilzen, Protozoen, Cyanobakterien und Viren. Wichtige Erkenntnisse aus diesem Fachgebiet schufen wiederum weitere Grundlagen, unter anderem für die moderne Gentechnik, …

Wettbewerbsvorteile durch Corporate Incubation
… minimieren und die Rendite steigern können
München, 12. Dezember 2013 – Die Gründerszene in Deutschland verzeichnet in den letzten Jahren eine starke Zunahme an Inkubatoren. Für Konzerne wird Inkubation als Bestandteil der Innovations- und Wachstumsstrategie immer bedeutender. Die Managementberatung Mücke, Sturm & Company hat die Chancen und Risiken …

Innovationsfähigkeit von Logistikdienstleistern: IPRI untersucht die Anwendung von Inkubatoren in der Logistikbranche
… regulatorische Anforderungen erhöhen den Druck auf die Branche. Darüber hinaus verschärfen globale Krisen und geopolitische Unsicherheiten die Situation.Mit Hilfe von Business Inkubatoren können Innovationen vorangetrieben werdenInkubatoren können ein entscheidender Treiber für die Entwicklung neuer Lösungen in der Logistikbranche sein. Sie bieten Zugang …


Wachstumsbeschleuniger für Unternehmen
Nürnberg – Unternehmen möchten wachsen und sich dabei weiterentwickeln. Wie das mithilfe von Inkubatoren gelingt, erfahren Sie beim 10. Nürnberger Unternehmer-Kongress am 20. Januar 2020 im NCC Ost der NürnbergMesse.
Erfolgreiches Wachstum ist sowohl für Start-ups wie auch für etablierte Betriebe ein wichtiger Faktor in der Unternehmensentwicklung.
Unterstützung …

Wiener Startup-Schmiede INiTS übertrifft 95 % der weltweiten Inkubatoren
Neueste detaillierte Daten der internationalen Forschungsinitiative UBI Index veröffentlicht
Das universitäre Gründerservice INiTS etabliert sich im internationalen Vergleich als einer der Top-Inkubatoren – vor allem in Bezug auf sein Netzwerk. Dessen Qualität und Größe übertrifft die Netzwerke von 95 % universitärer Inkubatoren weltweit. Detaillierte …


Berlin Summer School 2022 - Healthcare Transformation
… Andrea Belliger und Prof. Dr. Volker AmelungThemen der Summer School Healthcare Transformation - auf dem Weg zum ÖkosystemDigital Health Startups, Inkubatoren & InvestorenInnovation & Marktzugang: Perspektive Industrie & Versicherung-Value Proposition aus LeistungserbringerperspektiveLearning Journeys: Zu Besuch bei Digital Health Startups …


Weniger ist mehr
BINDER CO2 Inkubatoren mit ANTI.PLENUM DESIGN
Maximale Probensicherheit und bestmögliches Zellwachstum: Das ist es, was sich Laborbetreiber und Labormitarbeiter von einem Inkubator wünschen. Viele Anbieter versuchen, diesen Anforderungen mit immer neuen Zusatzfunktionen und Einbauten im Inkubator gerecht zu werden. BINDER jedoch verfolgt hier bewusst …
Sie lesen gerade: Alle Informationen zu Inkubatoren